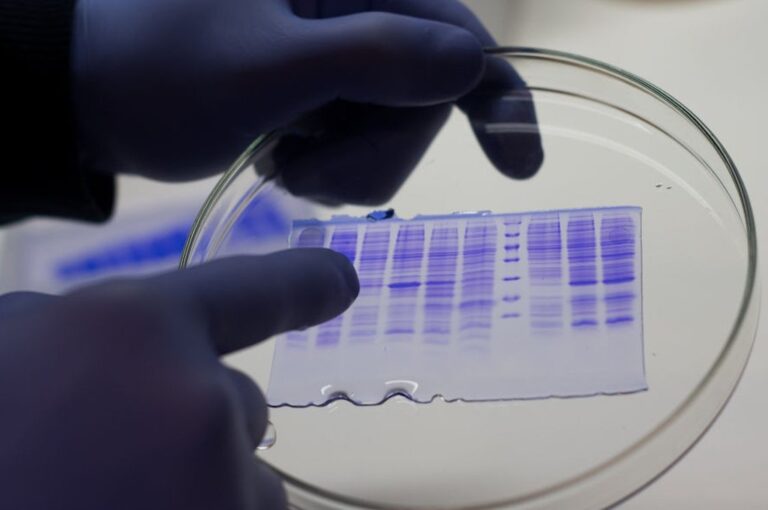
Captura de Google

Con Moderna
Comenzó este martes en Rosario y en la ciudad capital lo harán este miércoles.
Este martes comenzaron con la aplicación de la segunda dosis de la vacuna Moderna para adolescentes de 12 a 17 años con prioridad en la provincia de Santa Fe.
El operativo comenzó en Rosario y en la capital de la provincia harán lo propio este miércoles en el Hospital de Niños "Dr. Orlando Alassia" con 400 turnos.
En Rosario, la vacunación se realiza en el Hospital de Niños Zona Norte. En ese lugar se brindó una conferencia de prensa en la que participaron el coordinador de Dispositivos Territoriales del Ministerio de Salud de la Provincia, Sebastián Torres, y la directora de este centro de salud, Mónica Jurado.
El funcionario habló sobre la variante Delta. “Hasta el día de la fecha no hay circulación comunitaria a nivel país. Se está monitoreando de cerca. Los casos que hemos tenido son de personas que han sido viajeros. No hay más. El monitoreo nos permite hacer un seguimiento no sólo del caso índice, sino también de sus contactos estrechos. Con esto se ha logrado demorar la circulación comunitaria. Va a ser inminente, pero demorarla nos permite aumentar la vacunación”, manifestó.
Mientras que la médica puntualizó sobre la inoculación a adolescentes. “Son 28 días de diferencia con la primera dosis y hoy los primeros que recibieron la primera dosis empiezan a completar esquema”, expresó.
“Vemos en la presencialidad un hecho prioritario para recuperar a los niños en su sociabilización y en su aprendizaje. No tuvimos un aumento en la incidencia de covid porque los niños estén escolarizados. Los niños tienen que estar en la escuela con las condiciones de protocolo. Estar en el aprendizaje que lo necesitan y nosotros cuidarlos”, agregó Jurado.